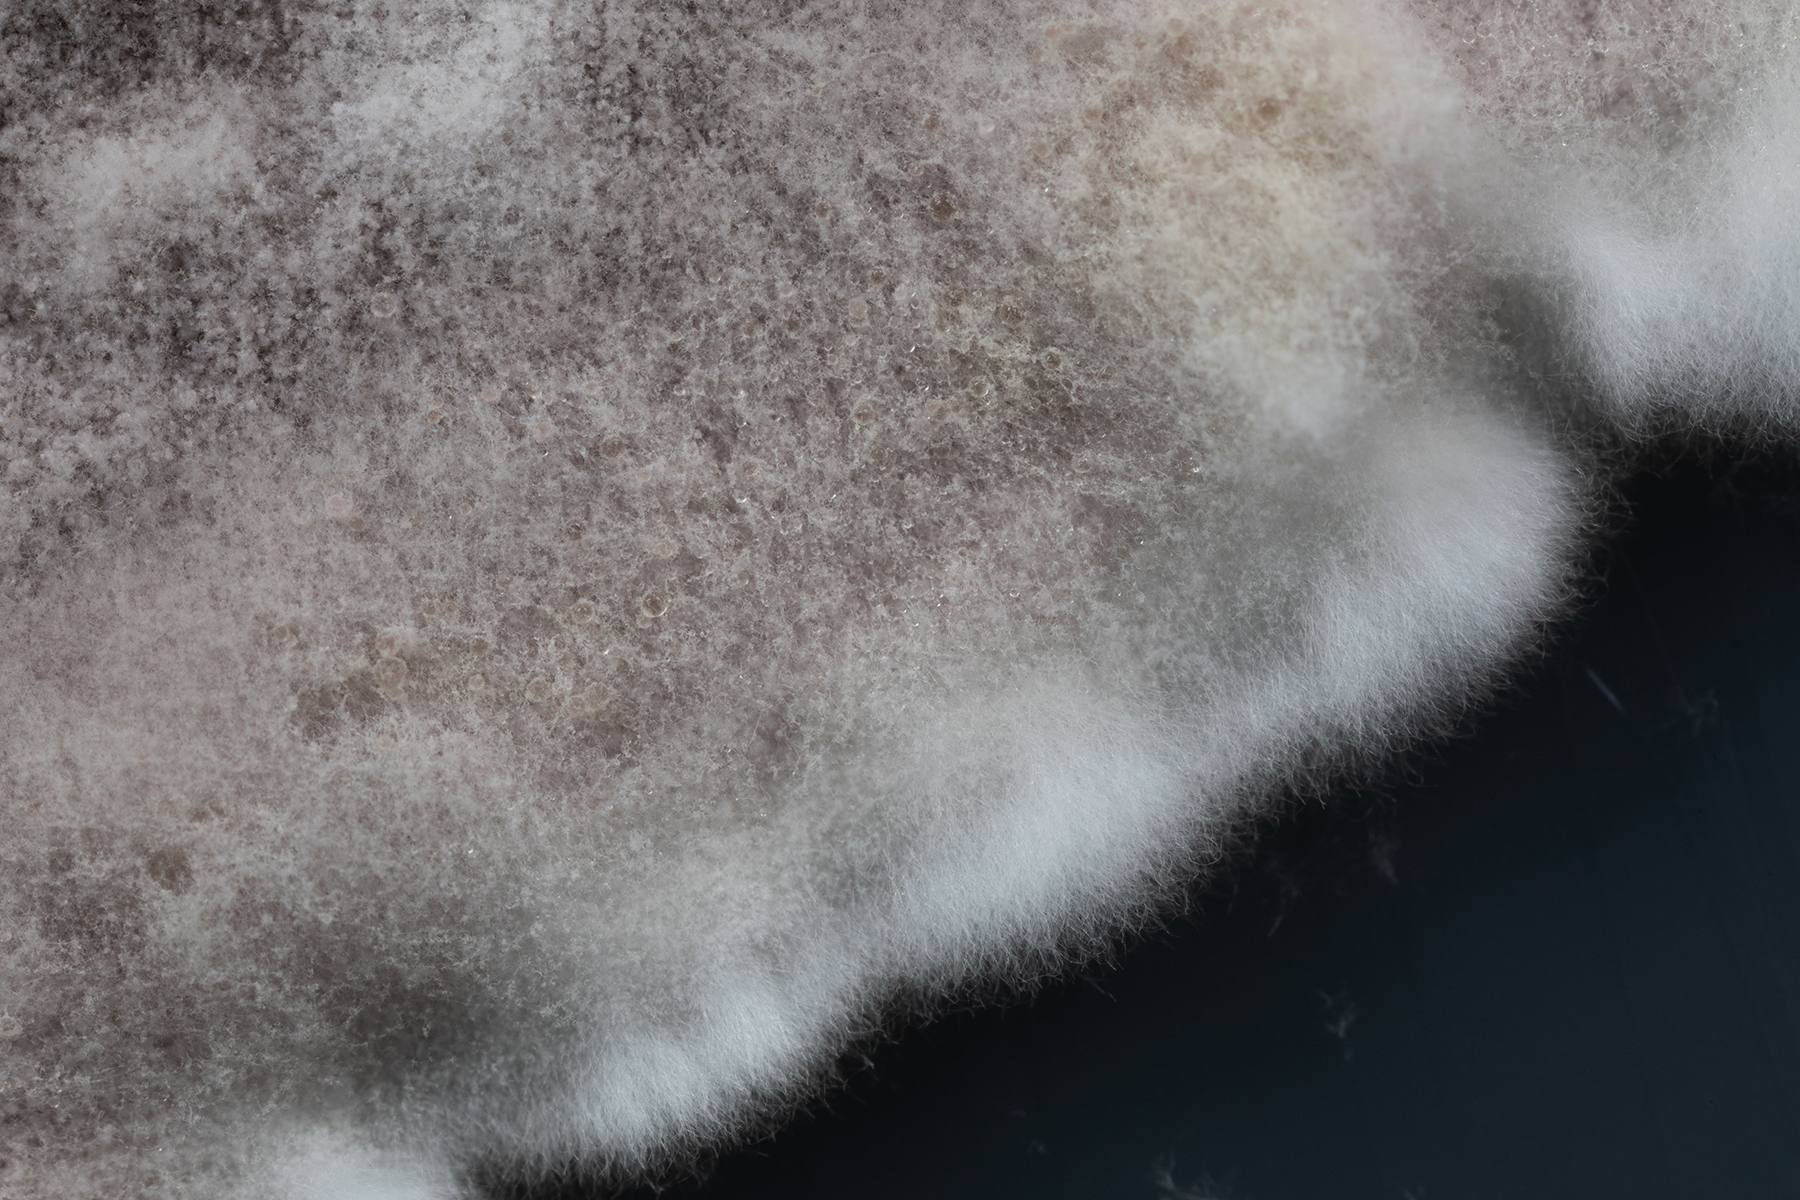

Solving Plant Health
Healthy plants start with healthy systems—roots, soil life, and natural defenses working together. But modern growing practices often disrupt these connections. Repeated planting, heavy chemical inputs, and simplified environments strip away microbial diversity and beneficial organisms, leaving plants more vulnerable to pests, diseases, and stress.
Soil amendments and biosolutions offer a way to restore that balance. By introducing beneficial microbes, silicon, amino acids, biofungicides, and other biological tools, growers can strengthen plant foundations and reduce reliance on synthetic inputs. These inputs don’t need to be applied all at once; true resilience comes from using the right solution at the right time and in the right place—whether that’s fortifying roots during propagation, boosting recovery after stress, or reinforcing defenses when pest pressure rises.
This approach builds a living, dynamic system where soil health, plant vigor, and natural pest control work in harmony. The result? Stronger roots, tougher tissues, and a thriving ecosystem that supports plants season after season.
To help growers build their own arsenal for success, we’ve curated a few plant health tools—each with its own role and labeled use.

New Recruits
Natural Enemies has recently enlisted three new products from Impello Biosciences. Each is designed to strengthen plant defenses in a unique way and help growers reduce setbacks from disease, insects, and stress.
Continuµm™ delivers a co-culture of plant growth–promoting rhizobacteria (PGPR) that colonize the root zone, improve nutrient availability, and create a living shield around roots. When the season turns rough—heat, drought, transplant shock, pest or disease pressure—this established community helps plants stay balanced so setbacks are smaller and bounce-backs are faster.
Dune™ supplies silicon as monosilicic (orthosilicic) acid, the highly available form plants can take up right away. That silicon becomes structural support—thicker, tougher cell walls that help plants stand up straighter, hold form in wind and heat, and are harder to damage. The formulation is stable and compatible, so it slots into foliar or fertigation without clogging emitters.
Lumina™ is an organic amino acid and peptide source produced by microbial fermentation (derived from molasses and shrimp protein hydrolysate). Plants can use these aminos directly as building blocks and chelating helpers—supporting micronutrient uptake, steady growth, and faster recovery after pruning, repotting, heat events, or pest cleanup.

Steady As They Go
Trianum-P is a long-lasting biofungicide that works preventatively, so it needs to be applied to plants ASAP—preferably during propagation. It acts as a bulwark against soil-borne diseases such as Fusarium, Pythium, Rhizoctonia, Cylindrocladium, and Thielaviopsis. Trianum-P takes a little time to get established and then coats the roots, keeping plants armored up until the next time those roots are disturbed, usually via replanting.
Unlike many conventional root fungicides, this biosolution allows plants to grow naturally in a healthy manner. Trianum-P contains the hybrid T-22 strain of the beneficial fungus Trichoderma harzianum. Once applied, the fungus grows very rapidly along the roots, forming a barrier along the surface and giving soil pathogens no room to establish. At the same time, Trianum-P out-competes soil-borne pathogens that feed on the same nutrients at the root zone. It then grows around the pathogens and produces enzymes that break down their cell walls, deactivating them.
Trianum-P also promotes a healthier root system with more root hairs, improving the uptake of water and nutrients. This results in stronger, more uniform plants, particularly when grown under sub-optimal conditions. Formulated for spray application and for use in overhead and drip irrigation systems, it’s gentle on plants and suitable for use in many field and greenhouse crops.

Boots In The Ground For Roots
Microflora SA is a quick hit to keep the soil healthy—in and out, fighter-jet style. As a microbial soil amendment, it enhances ornamental and food plant growth and improves yield. Microflora SA also boosts stress resistance.
A liquid, this product is a mixture of Plant Growth Promoting Rhizobacteria (PGPR) from the genus Bacillus. Microflora SA has been formulated to amplify plant development by improving the availability of plant nutrients through the root system. It needs to be reapplied on a weekly basis.
Bacteria colonize roots as they grow, so the effects will be more pronounced if Microflora SA is present as early in the plant’s life as possible. It can be applied via drench, spray, or dripping systems, or can be added in the furrow at seeding/planting or to the subsoil/potting soil for later use. Another method is to mix it with liquid fertilizers (including concentrates) or apply it on granular fertilizer (saturation).
Note: Effects may vary depending on soil type and existing microbial load. Cumulative benefits are more likely with consistent use.
Lying In Wait
Isarid™ is a garrison—always there, keeping a shield up against threats all the time. When bad actors hatch in the soil, Isarid™ is there to take care of them. This biosolution is a mycoinsecticide—a naturally occurring insecticidal fungus that’s safe to use around most beneficial insects.
It targets a wide range of ornamental pests, including whitefly, thrips, fungus gnats, mealybugs, aphids, and more. When spores of Isarid™ come into contact with an insect pest, they attach to the body and begin to grow almost immediately, resulting in the death of the pest.
The product works best in a pest management program designed to keep insect and mite populations below damaging levels. It can be integrated into an overall biocontrol strategy whenever pesticide use is necessary.
Note: While generally safe for beneficials, timing and application method should be considered to avoid overlap with sensitive species.

Natural Armaments From Natural Enemies
Plant health means more than just fighting off problems as they come up. It’s about building a complete, resilient ecosystem above and below ground, where strong roots, healthy soil, and vibrant leaves all work together. This kind of balance is needed from the very start (like planting or repotting), but it’s just as important during times of stress, when roots are disturbed, or when pests show up.
That’s why Natural Enemies offers a full lineup: beneficial microbes, silicon, amino acids, mycoinsecticides like Isarid™, and beneficial insects. Each one plays a different role, but together they help plants stand up to pests and disease, recover from setbacks, and thrive without relying on harsh chemicals. Because plants don’t develop resistance to these biosolutions, you can keep your ecosystem strong season after season.
Each of these biosolutions offers a different, complementary strategy for plant health:
- Continuµm™: A co-cultured community of beneficial bacteria that sets up around roots, unlocks nutrients, and helps plants stay vigorous or rebound from environmental pressures.
- Dune™: Stabilized monosilicic (orthosilicic) acid—silicon in the form plants actually use—to reinforce cell walls and help plants stand taller and tougher.
- Lumina™: Bioavailable amino acids and peptides from microbial fermentation that feed plants directly and support quick, gentle comebacks after stress.
- Trianum-P: Biofungicide that protects roots by forming a long-lasting barrier against soil-borne pathogens, giving them no room to establish and out-competing them for nutrients.
- Microflora SA: Microbial soil amendment that supercharges soil health and microbial diversity, creating a thriving environment for roots and beneficial organisms.
- Isarid™: A targeted mycoinsecticide that uses beneficial fungi to infect and control pest insects—offering biological pest management without chemical residues.
- Beneficial insects: Deliver powerful, ongoing natural pest defense by actively seeking out and suppressing harmful insects, keeping your ecosystem in balance.
Using these biosolutions together helps plants prevent, withstand, and recover from a wide range of challenges—reducing reliance on chemical interventions and building a healthier, more resilient growing environment.